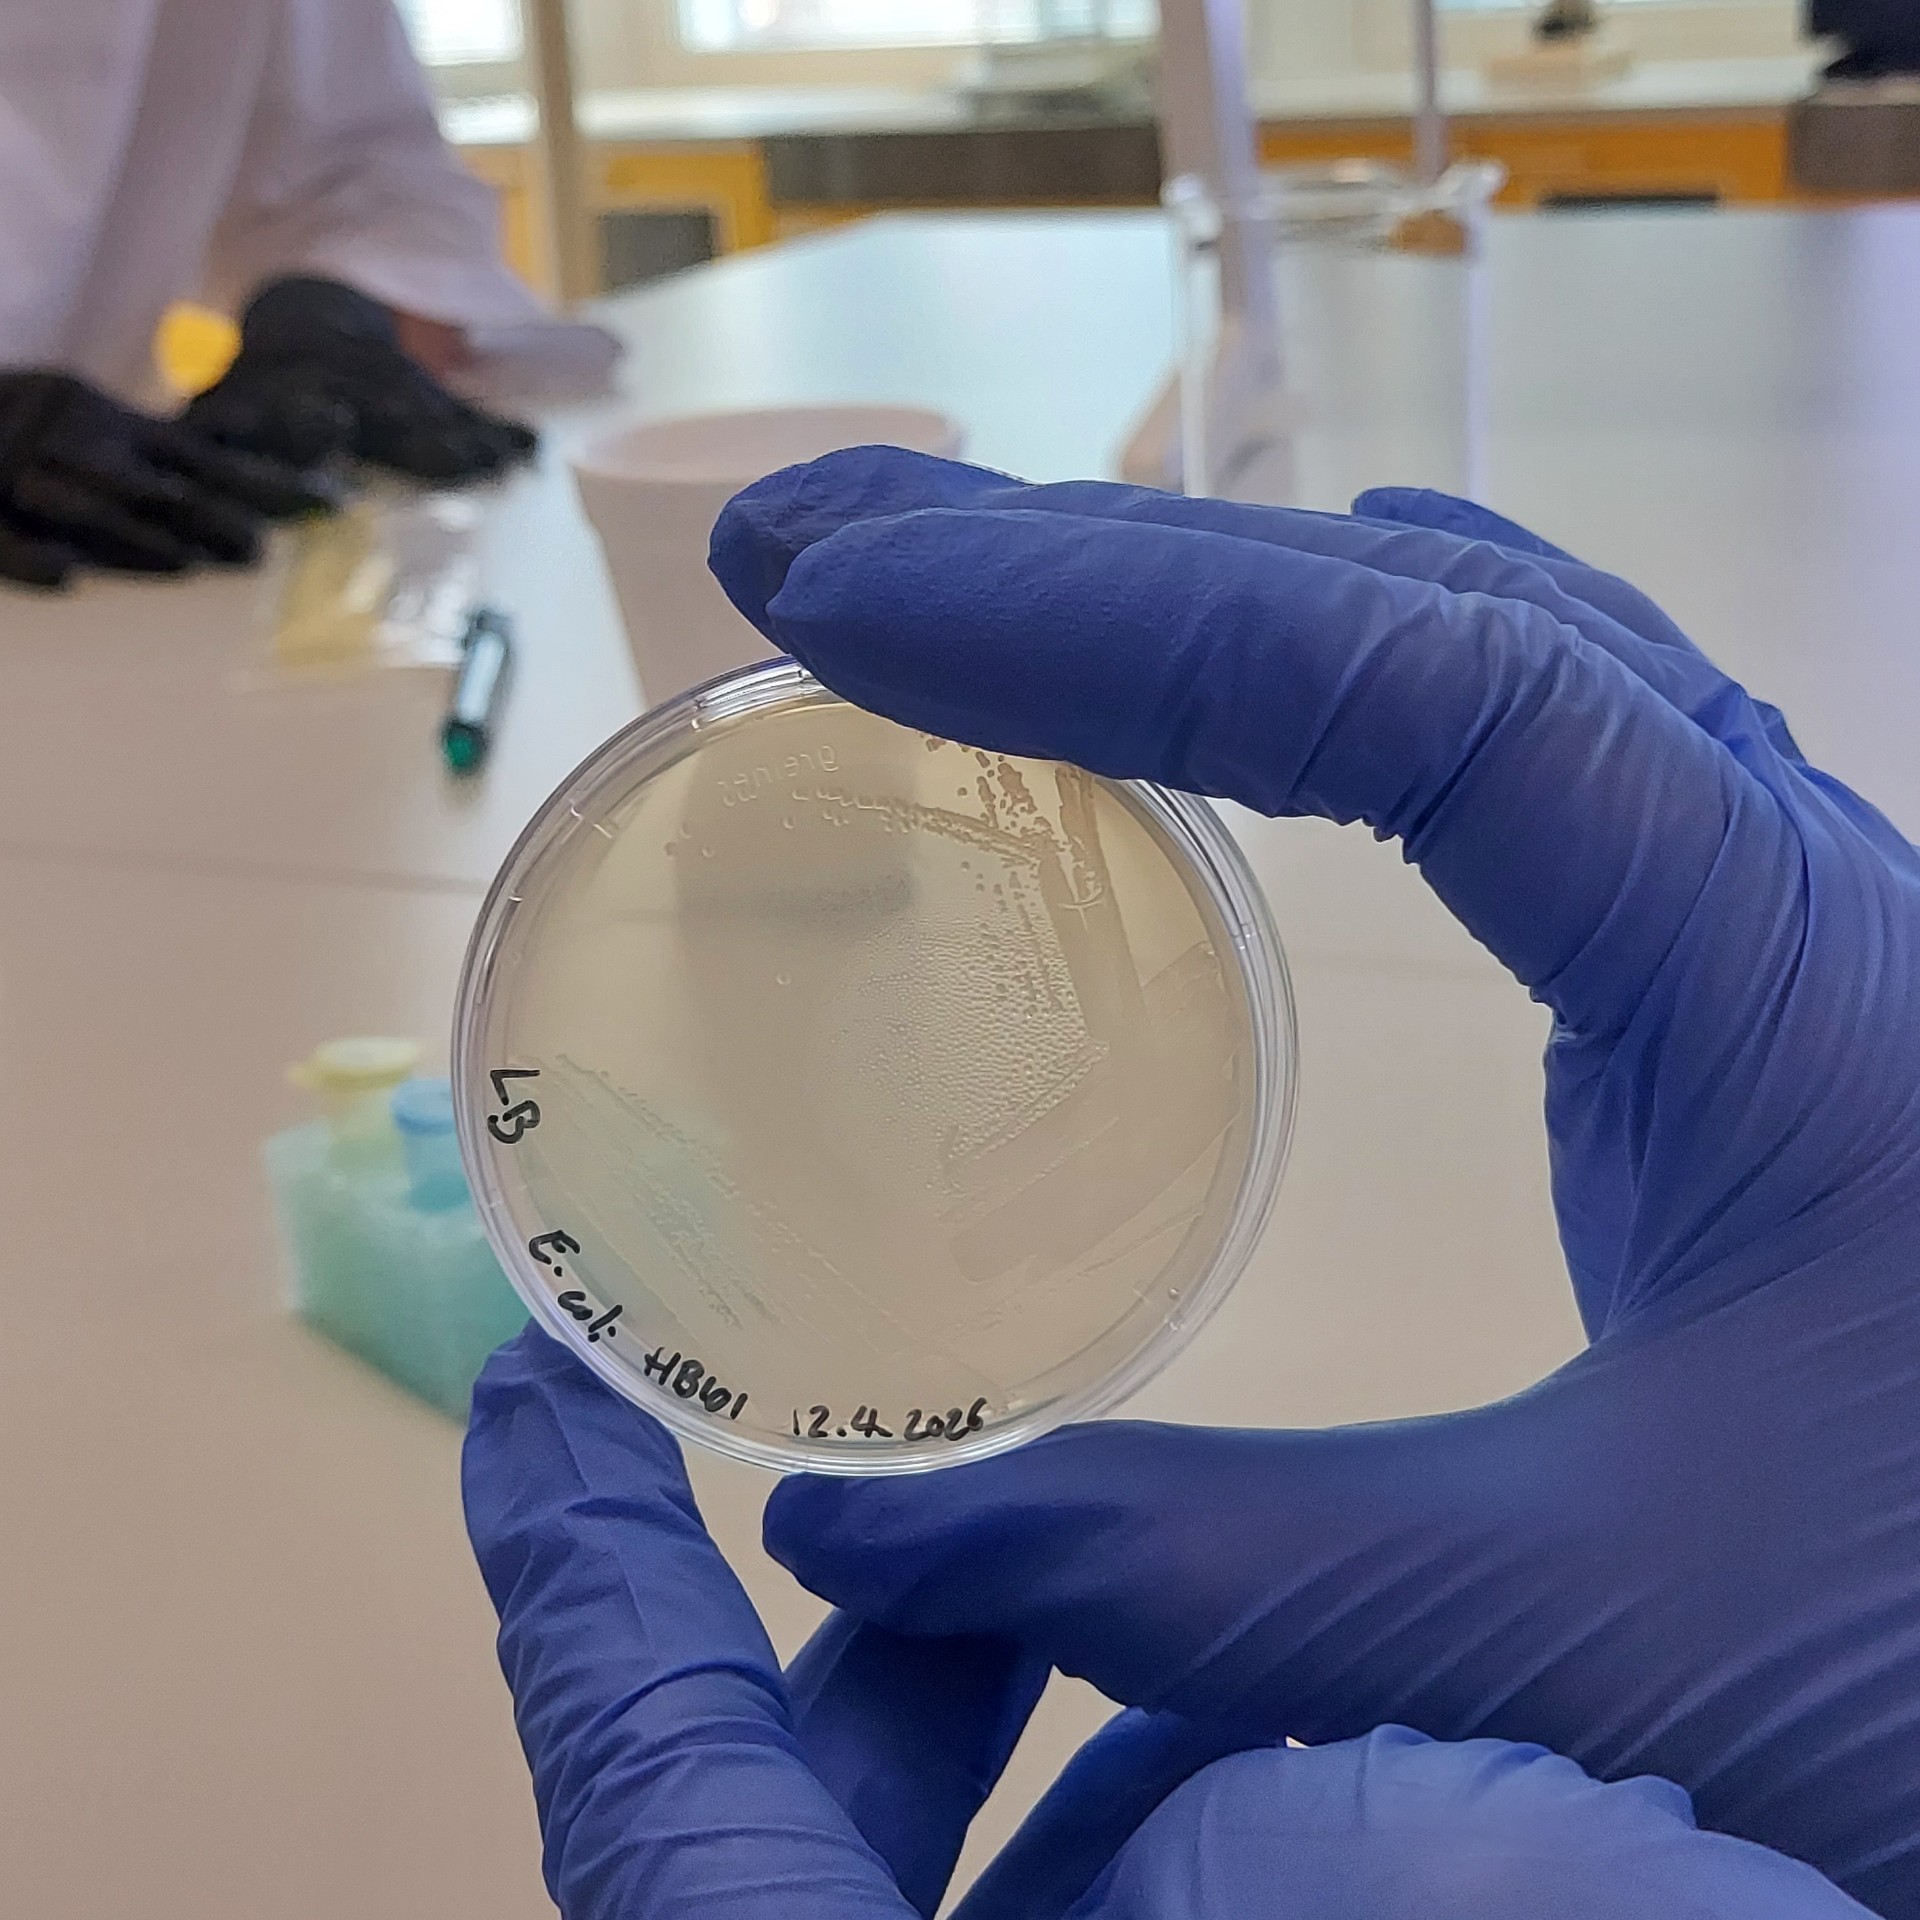

Luonnontiedelinjalaiset pääsivät tekemään geenisiirtoa Otaniemen lukiossa. Teoreettinen geenitekniikka saatiin käytännön tasolle. Hieno ja opettavainen aamupäivä.



MH
Luonnontiedelinjalaiset pääsivät tekemään geenisiirtoa Otaniemen lukiossa. Teoreettinen geenitekniikka saatiin käytännön tasolle. Hieno ja opettavainen aamupäivä.

MH